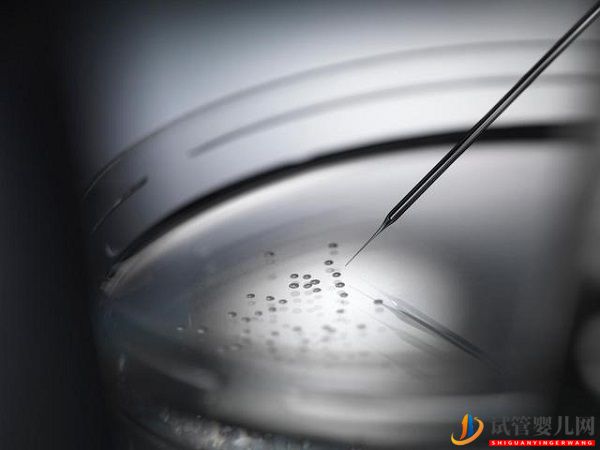
直觀分析試管嬰兒成功率高嗎(圖1)

?
成人h在线播放|
91国产成人在线|
国模叶桐国产精品一区|
动漫av网站免费观看|
√资源天堂中文在线|
欧美成人自拍|
亚洲美腿欧美偷拍|
成人在线视频国产|
日韩精彩视频在线观看|
欧美精品视频www在线观看|
97久久夜色精品国产九色|
人妻在线日韩免费视频|
成人免费毛片嘿嘿连载视频…|
国产在线播放一区二区三区|
亚洲国产97在线精品一区|
色99中文字幕|
国产成人在线网址|
老司机精品视频在线播放|
中文欧美字幕免费|
欧美黄色小视频|
无码内射中文字幕岛国片|
国产成人三级在线播放|
日韩极品在线观看|
精品少妇一区二区三区免费观看|
色女人综合av|
日本在线视频免费观看|
99精品视频精品精品视频|
欧美日韩中文在线|
99www免费人成精品|
日韩一区二区a片免费观看|
91免费精品国偷自产在线在线|
高清视频一区二区|
久久久91精品|
久久午夜夜伦鲁鲁一区二区|
天天干免费视频|
国产suv精品一区二区6|
日韩在线小视频|
亚洲成熟丰满熟妇高潮xxxxx|
国产高清第一页|
秋霞影院一区二区|
日韩黄色高清视频|
91免费黄视频|
午夜精品小视频|
精品午夜久久福利影院|
国产亚洲欧美视频|
欧美综合在线观看视频|
五月婷在线视频|
成人午夜在线播放|
久久中文久久字幕|
午夜一级免费视频|
欧美成人高清视频在线观看|
日本一区二区三区国色天香
|
亚洲欧美中文字幕|
91九色丨porny丨国产jk|
国产黄色av片|
国产成人欧美日韩在线电影|
久久精品视频中文字幕|
高潮一区二区三区|
国产精品亚洲欧美日韩一区在线|
国产精品久久久久一区二区三区共|
国产精品成人久久久久|
五月天综合视频|
日韩欧美字幕|
欧美片网站yy|
天天爱天天做天天操|
国产美女精品视频国产|
国产在线不卡一区|
久久成人这里只有精品|
手机在线观看日韩av|
日韩精品中文字幕一区二区|
一区二区三区在线视频免费
|
欧美一区二区三区红桃小说|
午夜久久久久久久久|
国产一区二区三区无遮挡|
久久久国产精品成人免费|
国产精品永久|
亚洲天堂免费观看|
国产三级三级看三级|
亚洲一区av|
亚洲欧美激情小说另类|
国产成人精品一区二区三区福利
|
999视频在线|
蜜臀精品久久久久久蜜臀|
日韩中文字幕欧美|
一级全黄裸体片|
日韩高清一级|
欧美日韩亚洲综合一区二区三区
|
一本色道久久|
亚洲欧洲黄色网|
国产一伦一伦一伦|
国产ts一区|
色综合av在线|
26uuu成人|
色网站免费观看|
中文av字幕一区|
成人看片在线|
丁香社区五月天|
国内久久婷婷综合|
韩国欧美亚洲国产|
国产黄色录像视频|
午夜欧美精品|
亚洲图片欧美日产|
又大又长粗又爽又黄少妇视频|
日韩在线你懂的|
精品视频在线看|
日韩网站在线免费观看|
男女啪啪999亚洲精品|
亚洲国产成人高清精品|
天天人人精品|
手机在线精品视频|
亚洲少妇中出一区|
欧美日韩国产精品一区二区|
av中文字幕免费|
久久蜜桃av一区二区天堂|
亚洲精品欧美一区二区三区|
久久久久亚洲av成人毛片韩|
国产成人精品一区二|
国产精品国产三级国产专播精品人|
性欧美videos|
美女视频网站久久|
日本视频久久久|
青青草精品在线视频|
轻轻草成人在线|
国内精品久久久久伊人av
|
欧美gayvideo|
日韩高清av在线|
国产精品久久久久野外|
欧美hd在线|
在线视频精品一|
亚洲av无码国产精品久久|
国产一区二区三区自拍|
久久精品国产一区|
蜜臀久久99精品久久久久久|
亚洲永久视频|
国模叶桐国产精品一区|
免看一级a毛片一片成人不卡|
久国产精品韩国三级视频|
国产精品7m视频|
久草手机在线观看|
av成人老司机|
国产伦精品一区二区三区照片91|
a毛片在线免费观看|
中文字幕综合网|
亚洲一区不卡在线|
黄页免费欧美|
欧美精品aⅴ在线视频|
五月婷婷狠狠操|
av一区二区在线播放|
亚洲精品在线不卡|
30一40一50老女人毛片|
西西裸体人体做爰大胆久久久|
久久久久久久久久久国产|
日本a级片视频|
国产精品资源网|
亚洲最大av在线|
a在线观看免费|
亚洲综合区在线|
国产乱淫av片杨贵妃|
jazzjazz国产精品久久|
精品国产免费久久|
色婷婷精品久久二区二区密|
国产婷婷精品|
日本欧美在线视频|
国产精品成人久久久|
国产精品久久久一本精品|
亚洲精品在线观看免费|
日韩三区四区|
日韩精品一区二区三区中文精品|
91精品人妻一区二区三区蜜桃2|
一区在线播放|
欧美一区二区色|
91视频在线视频|
亚洲情趣在线观看|
成年人视频网站免费|
欧美一区二区三区红桃小说|
亚洲人成免费电影|
成人做爰视频网站|
成人一区在线看|
欧洲一区二区在线观看|
gogo大尺度成人免费视频|
欧美成人伊人久久综合网|
亚洲av成人精品一区二区三区|
老司机午夜免费精品视频|
国产精品视频xxxx|
丁香六月色婷婷|
欧美性猛交xxxx乱大交3|
天天爽夜夜爽一区二区三区
|
国产精品高清一区二区三区|
色网站免费观看|
日韩欧美黄色动漫|
日韩av片专区|
国产亚洲一级|
国产剧情日韩欧美|
国产普通话bbwbbwbbw|
婷婷综合久久一区二区三区|
久久综合久久色|
欧美精品午夜|
2019日本中文字幕|
亚洲一区二区三区网站|
性做久久久久久免费观看欧美|
欧美一级黄色影院|
欧美日本不卡|
国产精品久久久亚洲|
午夜久久久久久久久久|
91黄色激情网站|
伊人影院在线观看视频|
肉肉av福利一精品导航|
成人羞羞视频免费|
青草综合视频|
亚洲国产日韩一区|
男人在线观看视频|
久久综合色之久久综合|
久久久久久久久久伊人|
日本一区二区高清不卡|
性色av一区二区三区|
国产精品视频一二区|
在线一区二区三区做爰视频网站|
天天久久综合网|
蜜臀av一区二区在线免费观看|
黄色99视频|
99亚洲乱人伦aⅴ精品|
日韩中文字幕视频在线|
免费黄色一级大片|
欧美日韩亚洲精品内裤|
无码人妻一区二区三区精品视频|
麻豆国产精品官网|
欧美日韩一区二区三区免费|
国内自拍欧美|
久久国产视频网站|
一级黄色片网站|
欧美伊人精品成人久久综合97|
特级西西人体wwwww|
成人动漫中文字幕|
日韩视频在线视频|
亚洲二区在线|
成人xxxxx色|
中文字幕一区二区三区中文字幕|
精品久久久91|
中文字幕在线播放日韩|
欧美性猛交xxxx乱大交退制版|
www.自拍偷拍|
久久久午夜精品|
国产淫片免费看|
亚洲一区二区网站|
精品伦精品一区二区三区视频
|
一区二区欧美视频|
亚洲欧美日韩一二三区|
国产呦萝稀缺另类资源|
国产一区一区三区|
66国产精品|
亚洲一区二区三区777|
日本在线一区二区三区|
欧美裸体男粗大视频在线观看|
国产巨乳在线观看|
日韩欧美在线不卡|
久久久久久久福利|
五月激情综合网|
丰满大乳奶做爰ⅹxx视频|
91麻豆精东视频|
日日碰狠狠躁久久躁婷婷|
日韩成人午夜精品|
中文字幕第一页亚洲|
欧美午夜一区|
精品视频第一区|
日日橹狠狠爱欧美超碰|
国产999精品在线观看|
久久av在线播放|
国产高清免费av|
亚洲激情免费观看|
国产精品视频123|
精品视频免费看|
精品国产乱码久久久久久鸭王1|
亚洲综合色网站|
aa片在线观看视频在线播放|
国产午夜精品一区二区三区四区|
在线观看免费视频高清游戏推荐
|
91九色国产ts另类人妖|
欧美日韩调教|
久久综合福利|
97偷自拍亚洲综合二区|
成人在线观看91|
九九在线高清精品视频|
国产精品偷伦视频免费观看国产|
国产精品久久久久久久久久久久久久久
|
中文字幕乱码在线观看|
欧美日韩一区精品|
青草草在线视频|
欧美这里有精品|
国产成人综合在线视频|
高潮白浆女日韩av免费看|
91精品久久久久久久久久久久|
**欧美大码日韩|
中文成人无字幕乱码精品区|
国产精品家庭影院|
黄色性视频网站|
中文字幕巨乱亚洲|
特级特黄刘亦菲aaa级|
国产午夜亚洲精品理论片色戒|
午夜av中文字幕|
久久久亚洲午夜电影|
日本黄色www|
国产精品素人一区二区|
中文文字幕文字幕高清|
国产精品国产a级|
亚洲午夜福利在线观看|
一区二区三区四区在线播放|
制服 丝袜 综合 日韩 欧美|
亚洲夂夂婷婷色拍ww47|
日韩av片在线免费观看|
日韩欧美精品网站|
久久久久久天堂|
欧美日韩国产电影|
日韩在线视频免费播放|
欧美成人一区二区三区片免费|
国产熟妇一区二区三区四区|
欧美成人乱码一区二区三区|
中文字幕乱码一区二区|
国产视频在线一区二区|
日本女人黄色片|
婷婷综合国产|
性欧美办公室18xxxxhd|
二区三区精品|
国产精品久久久久久久久男|
丝袜av一区|
国产一区在线免费观看|
自拍欧美日韩|
亚洲一区二区在线免费观看|
日韩和的一区二区|
日本免费黄视频|
a亚洲天堂av|
在线播放第一页|
一区二区三区四区不卡在线
|
国产精品乱人伦中文|
中文字幕在线免费看线人|
同产精品九九九|
亚洲一区二区91|
精品乱码亚洲一区二区不卡|
国产美女主播在线观看|
久久精品亚洲一区|
9999在线精品视频|
国产欧美精品在线播放|
色婷婷一区二区三区|
亚洲一区三区视频在线观看|
久久精品国产99久久6|
午夜欧美福利视频|
日本一区二区成人|
欧美福利第一页|
欧美日韩一区二区三区四区|
亚洲视屏在线观看|
色偷偷偷综合中文字幕;dd|
久久亚洲精品中文字幕|
国产精品永久免费观看|
99久久九九|
裸体裸乳免费看|
国产米奇在线777精品观看|
99精品视频国产|
亚洲激情自拍视频|
欧美被狂躁喷白浆精品|
日韩视频中午一区|
韩国av电影在线观看|
91国在线精品国内播放|
奇米777国产一区国产二区|
欧美高清性xxxxhdvideosex|
久久久久国产精品一区二区|
久久久久久香蕉|
国产精品久久久久久久蜜臀
|
91久久电影|
亚洲小视频在线播放|
国产91精品久久久久久久网曝门
|
91精品国产全国免费观看|
91福利在线观看视频|
九九热这里只有在线精品视|
国产精品极品在线观看|
久久久久久久久久久久久久久久av
|
精品蜜桃在线看|
午夜视频在线免费播放|
国产精品吊钟奶在线|
国产精品久久观看|
隔壁人妻偷人bd中字|
久久影院电视剧免费观看|
女人黄色一级片|
欧美大肚乱孕交hd孕妇|
性高爱久久久久久久久|
91精品啪在线观看麻豆免费
|
欧美va在线播放|
图片区 小说区 区 亚洲五月|
欧洲亚洲在线视频|
中文字幕日韩欧美精品高清在线|
日韩欧美猛交xxxxx无码|
久久中文娱乐网|
www.av免费|
亚洲开心激情网|
精品视频一区二区三区|
欧美不卡三区|
国产在线精品免费av|
中文字幕一区二区久久人妻网站|
欧美美女一区二区在线观看|
色婷婷激情五月|
成人在线激情视频|
国产精品综合|